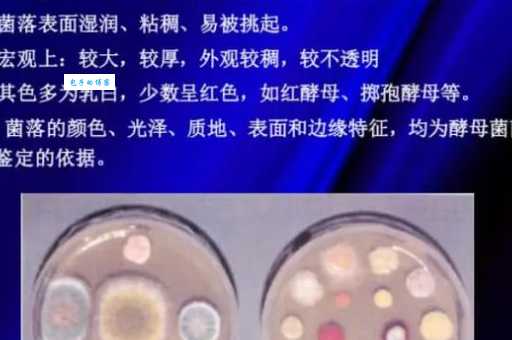
酵母菌是植物还是动物？它到底属于什么类型的生物？

嗨大家好!今天咱们来聊聊一个看起来很专业,其实一点也不难懂的酵母菌到底是个啥?属于哪类生物?说实话,一开始看到“酵母菌属于什么生物”这个我还小小地紧张了一下。毕竟,生物...
嗨大家好!今天咱们来聊聊一个看起来很专业,其实一点也不难懂的酵母菌到底是个啥?属于哪类生物?
说实话,一开始看到“酵母菌属于什么生物”这个我还小小地紧张了一下。毕竟,生物学这玩意儿,上学那会儿可没少让我头疼。各种细胞、菌类、分类,简直像绕进了迷宫一样。但后来想想,其实没那么复杂啦!咱们就用轻松的方式来理解它,就像跟朋友聊天一样,保证你听完就懂!
咱们得知道,酵母菌可不是什么庞然大物,它其实是一种单细胞生物。啥意思呢?就是说,它只有一个细胞!不像我们人类,是由数不清的细胞组成的。想想看,一个细胞的小家伙,能干啥呢?别小看它!它可是酿酒、做面包、甚至还能在某些药里发挥作用的“小能手”!
那么,这只有一个细胞的酵母菌,到底属于哪类生物呢?答案是:真菌!没错,就是和蘑菇、霉菌那些家伙是一家子的。你可能会问,真菌是啥?简单来说,真菌就是一类不含叶绿素,不能进行光合作用的生物。它们得靠吸收其他生物体里的营养来生存。所以,酵母菌也是靠“吃”东西来活着的,可不是靠晒太阳!
更具体一点说,酵母菌属于单细胞真核生物。 “真核”这两个字听起来很高大上,其实也很简单。它指的是酵母菌的细胞里有一个真正的细胞核,不像一些更简单的生物,细胞核只是个“简易版”。有了这个真核,酵母菌就能完成更复杂的生命活动。
为了更清晰地展现酵母菌的特点,我做了个大家可以看看:
| 特征 | 描述 |
|---|---|
| 细胞结构 | 单细胞,真核细胞,有细胞壁、细胞膜、细胞核等 |
| 营养方式 | 异养,通过吸收有机物获取能量 |
| 繁殖方式 | 主要为出芽生殖,也有其他方式 |
| 生存环境 | 在有氧和无氧环境下都能生存(兼性厌氧) |
| 用途 | 酿酒、烘焙、医药等 |
是不是一目了然?是不是一点也不复杂?
想想看,我们平时吃的面包,喝的啤酒,甚至某些药物,都跟酵母菌脱不了关系。它在发酵过程中扮演着重要的角色,让面包蓬松柔软,让啤酒香醇可口。所以说,这小小的酵母菌,可真是个“功臣”!
当然,酵母菌也不是只有好处。有些酵母菌会引起食物腐败,甚至某些种类还会导致人体疾病。所以,咱们不能一概而论,要具体问题具体分析。
酵母菌就是一个很神奇的小家伙,它虽然只有一个细胞,却在我们的生活中扮演着重要的角色。 了解了它的“身份”——单细胞真核真菌——之后,是不是觉得它也没那么神秘啦?
说到这里,我突然想到一个除了酿酒和烘焙,你还知道酵母菌有哪些其他的用途呢?或者你对酵母菌还有哪些好奇的地方?欢迎大家在评论区分享你们的看法!